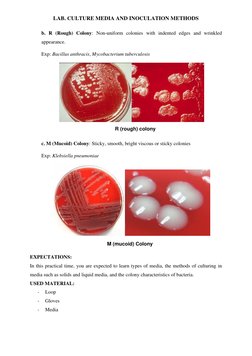
LAB. CULTURE MEDIA AND INOCULATION METHODS 
M (mucoid) Colony 
b. R (Rough) Colony: Non-uniform colonies with indented edges

100% found this document useful (1 vote)
1K views7 pagesCulture Media and Inoculation Methods
The document discusses culture media used in microbiology labs, including liquid, semi-solid, and solid media classified by physical state and chemical composition. It also describes methods for culturing microorganisms on solid media using streak plating techniques and observing colony characteristics. The goal is for students to learn about media types, culturing methods, and identifying bacterial colonies.
Uploaded by
ekin reyhanCopyright
© © All Rights Reserved
We take content rights seriously. If you suspect this is your content, claim it here.
Available Formats
Download as PDF, TXT or read online on Scribd
100% found this document useful (1 vote)
1K views7 pagesCulture Media and Inoculation Methods
The document discusses culture media used in microbiology labs, including liquid, semi-solid, and solid media classified by physical state and chemical composition. It also describes methods for culturing microorganisms on solid media using streak plating techniques and observing colony characteristics. The goal is for students to learn about media types, culturing methods, and identifying bacterial colonies.
Uploaded by
ekin reyhanCopyright
© © All Rights Reserved
We take content rights seriously. If you suspect this is your content, claim it here.
Available Formats
Download as PDF, TXT or read online on Scribd
- Introduction to Culture Media
- Methods of Culturing Microorganisms
- Colony Types on Culture Plates
- Expectations and Used Materials